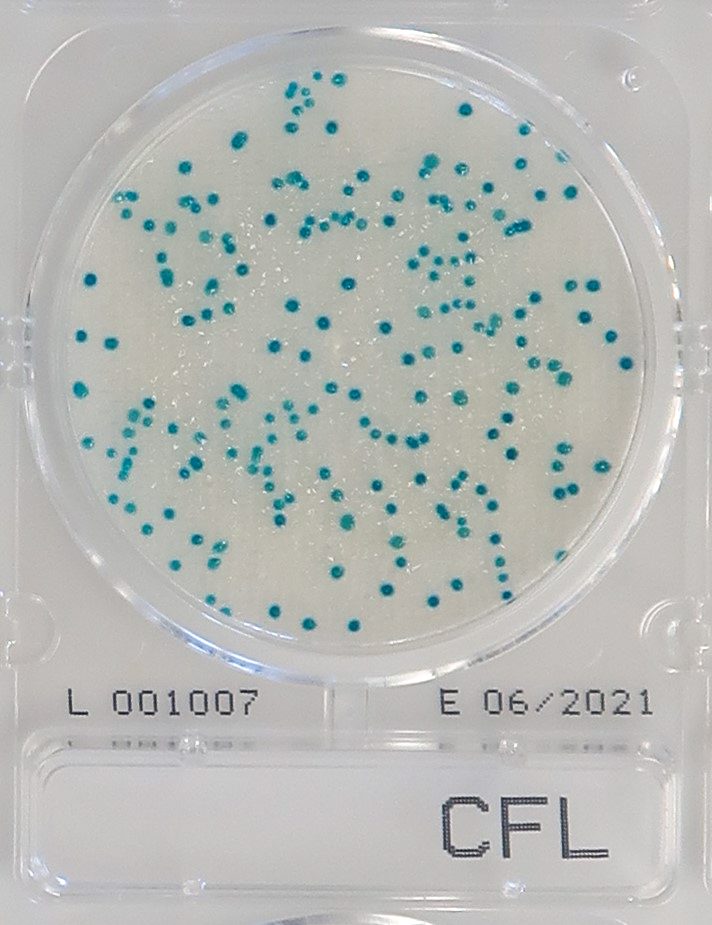

CompactDry CF-L
Coliforms are gram-negative, facultative anaerobic, non-spore forming bacteria and commonly found in animal intestines and soil. The term “coliform” refers to enteric bacteria found in foodstuff such as meat, shellfish, dairy products, other foods and in particular, water.
Bacteria such as Shigella, Salmonella, Yersinia, Citrobacter, Klebsiella, and Enterobacter are all coliforms, but the most recognized coliform is Escherichia coli.